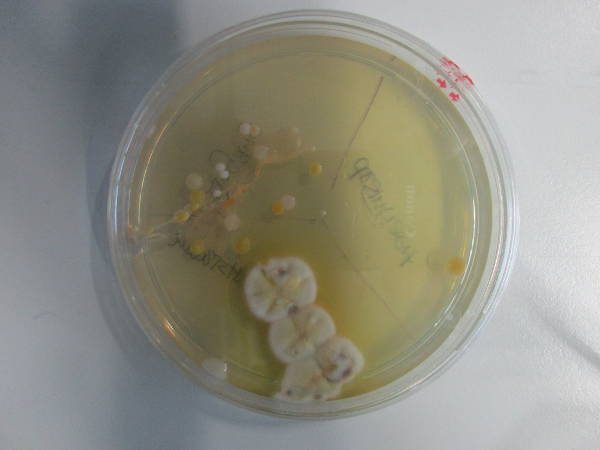

Bakterien überall
Wir begegnen den Bakterien tagtäglich, ohne es zu bemerken. Die winzig kleinen Mikroorganismen kommen überall und auf allen möglichen Flächen und Gegenständen vor, doch sie sind für uns Menschen mit bloßem Auge nicht sichtbar. Meistens werden wir uns ihrer erst bewusst, wenn sie unserem Körper Schaden zugefügt haben und für eine bakterielle Infektion verantwortlich sind.
Deshalb wollten die Klassen 8a und 8b herausfinden, wo in unserem Alltag vermehrt Bakterien vorkommen. Dieses Projekt wurde von der Studentin A. Kramer im Zuge ihres Professionalisierungspraktikums durchgeführt und mit dem Aufstellen von Hygienetipps abgerundet.